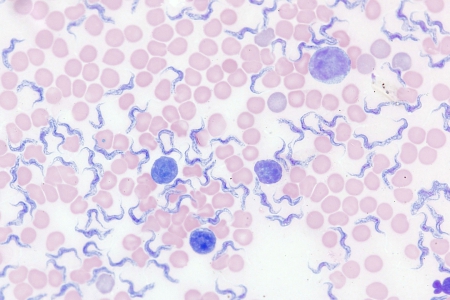
血跡、Giemsa染色、透射光明場
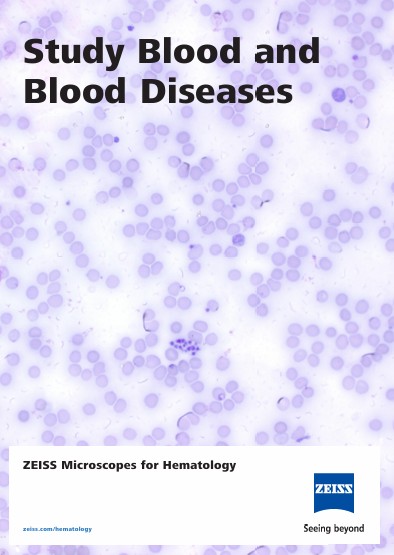
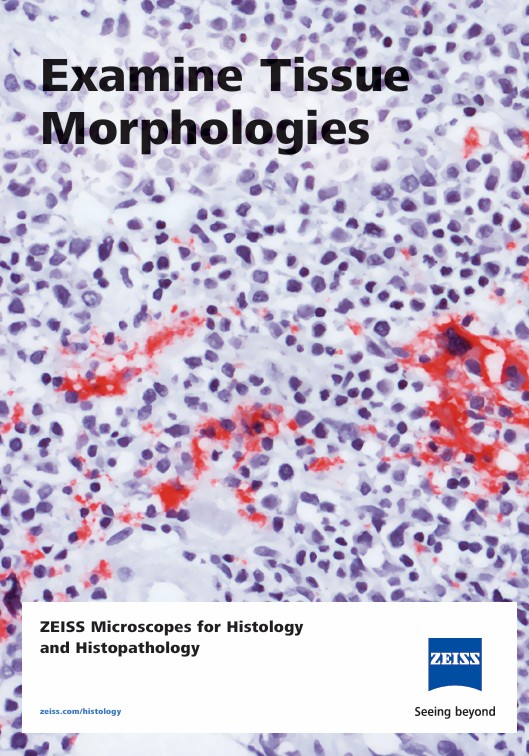

ZEISS Axiolab 5 蔡司中低階正立顯微鏡
利用智慧顯微鏡優化臨床與生物醫學實驗室效率
蔡司 Axiolab 5 工作現場
相關應用
|
蔡司的臨床顯微鏡→ |
細胞學與細胞病理學的顯微鏡解決方案→ |
血液學顯微鏡解決方案→ |
|
微生物學顯微鏡解決方案→ |
組織學與組織病理學的顯微鏡解決方案→ |
分析顯微鏡解決方案→ |
檔案下載
|
ZEISS Axiolab 5→
|
ZEISS Axiolab 5 - Flyer → |
ZEISS Microscope for Cytopathology→ |
|
ZEISS Microscopes for Hematology→ |
ZEISS Microscopes for Histology→ |
Your microscopes for your biomedical laboratory→ |